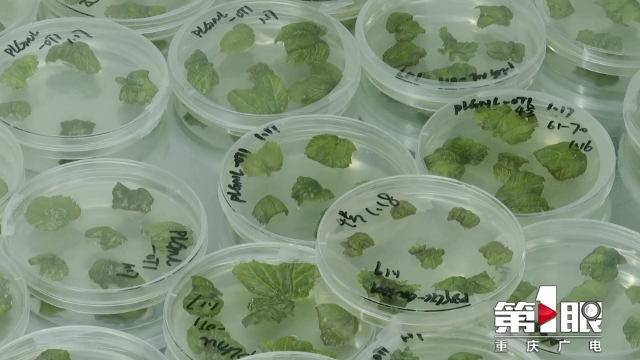
2.png

近日,betway88西汉姆联何宁佳教授团队在桑树基因研究领域取得又一重大突破,为相关生物种质资源研究提供了一条新的思路。
早在2013年,何宁佳教授团队在一次实验中偶然发现,不同桑树的染色体基数可以是14对,也可以是7对。随后,他们花费了近9年时间,对这一发现开展深入研究,力图揭开桑树染色体的“分”与“合”之谜。目前,研究团队已创造性地提出了“桑树染色体断裂-融合循环”理论。

betway88西汉姆联家蚕基因组生物学国家重点实验室副主任、教授何宁佳介绍,他们发现7对染色体的基数和14对染色体基数之间,实际上存在着一部分染色体融合、一部分染色体断裂的关系,它们不是简单的2:1的关系,14对中好几条多的染色体融合成7对的一条染色体,这个之间的对应关系其实是很复杂的。

这项研究成果,打破了以往人们认为一种生物就只有一套“染色体基数”的思维模式,它不但填补了桑树遗传基因组领域的空白,更为今后该物种的远缘杂交育种、产业发展以及其他基础研究工作,提供了更为精确的指导。

中国工程院院士向仲怀说:“所以它既是我们科学的基础,又是我们作为产业发展的理论基础。过去我们只讲栽桑养蚕,桑树只能够养蚕,现在我们要重新来构筑一个产业科学的体系。”
